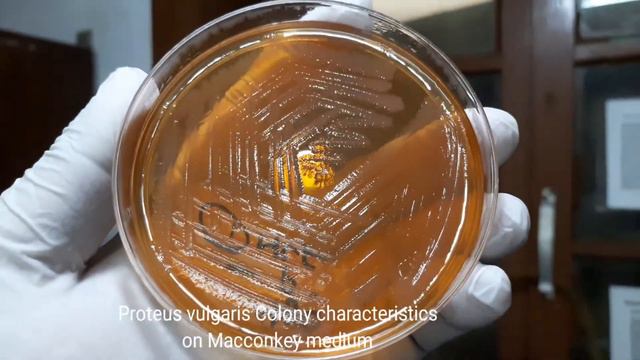
Proteus Vulgaris Colony Characteristics On Macconkey Agar

Зеленый путешествие - Новые видео
-
-
廣東酸梅鴨:酸甜開胃,嫩滑入味,簡單易學的美味佳餚❗,【天天相見廚房阿鵬哥】,#酸梅鴨料理,#酸梅鴨食譜,#酸梅鴨的做法, #酸梅鴨肉的做法大全,#酸梅鴨醬料,#廣東酸梅鴨,#美味佳餚,#美味酸梅鴨
以下是酸梅鴨的食譜: 材料: - 1只鴨子(約2-2.5公斤) - 適量的鹽和胡椒粉 - 2湯匙酸梅醬 - 2湯匙白糖 - 1湯匙生抽 - 1湯匙老抽 - 2顆大蒜,切碎 - 1片姜,切碎...
Смотреть -
ASMR ИТИНГ ОТ КОТОРОГО МУРАШКИ РВУТ РУБАШКУ💥/ASMR ЕATING💥
Спасибо за просмотр! Мой вк: https://vk.com/kirusum Мой тг: https://t.me/KristinOchkaASMR Мой бусти: https://boosty.to/krismuson 💋Поддержать канал: ...
Смотреть -
16 March 2022: Rise Of The Kings - Fast Castle Development & Alliance League Quest 💜
Hello everyone. I have recorded the Fast Castle Development Event so that old and new players can do this and get 1000 glorious medals by completing tas...
Смотреть -
WHAT'S IN MY DIAPER BAG FOR TODDLER & BABY || SPRING & SUMMER EDITION || ITZY RITZY DIAPER BAG
Hi lovies! Today’s video is What’s in my diaper bag for toddler & baby. I have 2 beautiful daughters. So if you wanna see what I have in my diaper bag f...
Смотреть -
HTF Mellow Katie's Furry Tale Theater Jackson And The Beanstalk
Princess Mellow Katie Jackson and the Beanstalk Nutty Squirrel A Blood Disney + Fandom Newground FirstCom Music Hello Kitty SpongeBob SquareP...
Смотреть -
Кто думает о Вас ?
Выбор позиции: 3:34 1️⃣ позиция - 5:32 2️⃣ позиция - 39:27 За консультацией Таролога обращайтесь (пишите) в WhatsApp Viber+375336212013 Подписка, лайк ...
Смотреть -
Как спорт влияет на иммунитет.
А вы задумывались о том, как связаны иммунитет и физическая нагрузка? 🤔 Сегодня наш фитнес-эксперт Павел Сыроежкин расскажет: ⠀ ⚡️ Как спорт влияет на и...
Смотреть -
-
-
-
Gardenia Demo
Ein kleiner Einblick in das Spiel Gardenia. #simulation #abenteuer #gelegenheitsspiel #indie # garten
Смотреть -
As Ducks Go Up 7 23 22
Broadcasted live on Twitch -- Watch live at https://www.twitch.tv/setarii
Смотреть -
-
Подборка музыкальных видеоклипов в программах Виктора Фанайлова.
Музыкальные номера и сюжеты, посвященные творчеству и увлечениям молодежи Воронежа середины 90 годов.
Смотреть -
Homeopathic Remedies For Households Part 1
This webinar, part one of two, covers 25 homeopathic remedies (A-L) that are very useful for common injuries, illnesses and complaints. Detailed descrip...
Смотреть -
CHOMP CITY!!! We Add 7 NEW Chomps To Our Collection Of Abominable Toys! Including NYCC Chomps!
We just got 7 New Chomps in the mail, so we go through our entire Abominable Toys collection! Including every NYCC Chomp that we know about! Our P.O. ...
Смотреть -
-
Spring Trials 2023: Ball FloraPlant
Join GrowerTalks and Green Profit Magazine editors as they tour PanAmerican’s trial location at the 2023 California Spring Trials. Check out an amazing ...
Смотреть -
Proteus Vulgaris Colony Characteristics On Macconkey Agar
Proteus vulgaris colony characteristics on Macconkey agar, Proteus vulgaris colony morphology , Proteus growth, Proteus on MacConkey agar, P. vulgaris c...
Смотреть